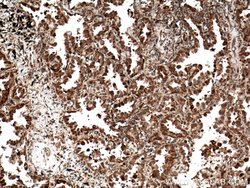
C21orf2 Rabbit anti-Human, Polyclonal, Proteintech 150 &mu;L; Unconjugated:Antibodies,

missing translation for 'onlineSavingsMsg'
Learn More
Learn More
C21orf2 Rabbit anti-Human, Polyclonal, Proteintech
Rabbit Polyclonal Antibody
Brand: Proteintech 27609-1-AP-150UL
This item is not returnable.
View return policy
Description
Four alternatively spliced transcript variants encoding four different isoforms have been found for this nuclear gene. All isoforms contain leucine-rich repeats. Three of these isoforms are mitochondrial proteins and one of them lacks the target peptide, so is not located in mitochondrion. This gene is down-regulated in Down syndrome (DS) brain, which may represent mitochondrial dysfunction in DS patients.Specifications
| C21orf2 | |
| Polyclonal | |
| Unconjugated | |
| C21orf2 | |
| A2, C21orf HUMF09G8.5, C21orf2, YF5, YF5/A2 | |
| Rabbit | |
| Antigen Affinity Chromatography | |
| RUO | |
| 755 | |
| -20°C | |
| Liquid |
| Immunohistochemistry (Paraffin), Western Blot | |
| 0.3 mg/mL | |
| PBS with 50% glycerol and 0.1% sodium azide; pH 7.3 | |
| O43822 | |
| C21orf2 | |
| C21orf2 Fusion Protein Ag26470 | |
| 150 μL | |
| Primary | |
| Human | |
| Antibody | |
| IgG |
Product Content Correction
Your input is important to us. Please complete this form to provide feedback related to the content on this product.
Product Title
Spot an opportunity for improvement?Share a Content Correction